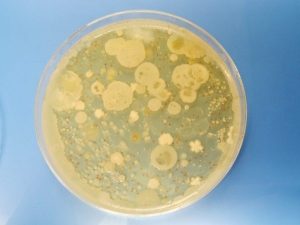

先日食品棚を整理していたら、ダイエット目的で料理やデザートに使うために買い置きしていた寒天が賞味期限切れになっているのに気づきました。
乾燥している寒天なら腐りそうにないし賞味期限切れでも大丈夫な気がしますが、子供のおやつに使えるか不安だったので、今回は寒天の賞味期限について以下の項目を調べてみました。
- 賞味期限切れの寒天は食べても大丈夫?
- 寒天は腐るとどうなるの?
- 寒天の正しい保存方法とは?
- 寒天は冷凍保存もできる?
- 寒天がダイエットにおすすめな理由とは?
乾燥したままの寒天なら日持ちしますが、開封後や水に戻した寒天の賞味期限はどうなのでしょうか。
牛乳と缶詰のみかんを入れた寒天ゼリーは子供も食べられるのでよく作っていたのですが、牛乳やフルーツが入っていると賞味期限は短そうですよね。

最近、健康志向の知人への贈答用に選んだ「たねや」の寒天トマトも、賞味期限は15日とそれほど長くありませんでした。
賞味期限の表示があればいいですが、手作りの場合は自分で判断するしかありませんよね。
この記事では、寒天の賞味期限や正しい保存方法などを徹底的に調査した結果をわかりやすく紹介していますので、ぜひ最後までご覧ください!
目次
賞味期限切れの寒天は食べられる?いつまで大丈夫なの?
寒天は日持ちする食材ですが、賞味期限切れだと本当に食べても大丈夫なのかと不安を感じるのも当然ですよね。

賞味期限が切れた寒天を食べても良い期間の目安を調べてみました。
寒天の賞味期限は乾物なら長い!
寒天の賞味期限はほとんどが2年から3年で設定されていますが、乾物なので賞味期限を数年過ぎても食べられます。
寒天には棒寒天、細寒天(糸寒天)、粉寒天などの種類があり、形状や寒天の原材料になる海藻も異なりますが、賞味期限については乾物のままなら2年~3年で設定されているものが多いです。
しかし、一旦水に戻した寒天の賞味期限は短いです。

牛乳やフルーツ入りの寒天は冷蔵保存で2日~3日が目安で、何も混ぜていないプレーンの寒天でも3日~5日が目安です。
市販の寒天だと製法によってもう少し長いものもありますが、それでも2週間程度ではないでしょうか。
例えば、ネット販売もしている「たねや」の寒天は、日持ちは15日で決して長くはないですよね。
寒天の賞味期限は短くて2日~3日、乾物だと数年と賞味期限の違いがありますが、賞味期限とはどういう意味なのでしょうか。
賞味期限とは
食品には賞味期限または消費期限の表示が義務付けられており、寒天に表示されているのは賞味期限です。
- 賞味期限・・・美味しく食べられる期限のこと
- 消費期限・・・安全に食べられる期限のこと
賞味期限は品質が劣化しにくい食品に付けられる表示です。
寒天は乾物のままであれば長期間の保存が可能なので、賞味期限が表示されています。
一方、消費期限はおにぎりやサンドイッチなど腐りやすい食品につけられる表示です。

消費期限を過ぎて腐ったものは食べられませんが、寒天は賞味期限切れでも腐りにくいので食べられます。
しかし、加工された寒天は違います。
一旦水に戻すと腐りやすくなりますし、牛乳やフルーツなどを混ぜると日持ちしなくなります。

とくにみかんなどの水分が多いものを入れると、日持ちが悪くなります。
寒天は長持ちするから大丈夫と思っていたら腐っている場合も!
では寒天は腐るとどうなるのでしょうか。
寒天は腐るとどうなるの?その見分け方はコレ
乾物のままの寒天は腐ることはほぼないですが、水に戻した寒天は腐りやすくなります。
水に戻すと菌が繁殖しやすくなるからです。

寒天が腐るとどのような変化が見られるのか、特徴を確認しておきましょう。
腐った寒天の特徴
- 緑色のカビが生える
- どろっと水っぽくなる
といった特徴があります。
寒天の原料は、テングサやオゴノリといった紅藻類から抽出される粘液質です。

寒天が製品化されるまで
- テングサやオゴノリから抽出した液体を凝固させる
- 凝固させた寒天を凍結させる
- 解凍、凍結を繰り返し水分を蒸発させる
- 水分が蒸発し乾燥したら寒天のできあがり
寒天は解凍と凍結を20日程繰り返して作られるのですが、寒天を水に戻すと腐るなら製造工程で腐らないの?と疑問に思いますよね。
寒天は冬場に作られることがほとんどなのです。

理由は簡単で、気温が高いと製造過程で腐ってしまうからです。
ということは、水に戻した寒天でも冷凍すれば日持ちするのでしょうか。
次は寒天の正しい保存方法を見ていきましょう。
寒天の正しい保存方法とは?冷凍してもいいの?
寒天をできるだけ日持ちさせて美味しく食べるには、正しい保存方法を守ることが大切です。
水に戻した寒天はカビが生えて腐ってきます。
手作りの寒天デザートなどは冷蔵庫で保存し、2日~3日を目安に食べきるようにしましょう。
市販の寒天ゼリーなども冷蔵保存で、期限を守って食べきりましょう。
水に戻した寒天をどうしても賞味期限内に食べ切れそうもない場合は、冷凍保存できると日持ちしそうですが、果たして冷凍保存はできるのでしょうか。
寒天は冷凍保存に向かない理由
結論から言うと、寒天は冷凍保存できません。

寒天はもともと冷凍と解凍で水分を蒸発させて作られたものです。
水に戻した寒天を冷凍しても、解凍した時に水分が抜けてスカスカになってしまいます。
寒天は冷凍保存に向かないので、冷蔵保存で賞味期限内に食べきるのが正しい保存方法であることを覚えておきましょう。
乾物の寒天の保存方法は?
水に戻す前の寒天の保存方法は以下のとおりです。
- 直射日光や高温多湿を避けて常温保存する
- 棒寒天や細寒天は袋に入れ、粉寒天は密閉容器に入れて保存する
乾燥している寒天も水分を含むとカビが生えてしまうので、乾燥状態を保持して保管するのがポイントです。

長期間保存して見た目が変わった寒天は大丈夫?
寒天を長期間保存していると、見た目が以下のように変わる場合があります。
- 黄色に変色
- 粘度や強度が弱くなった
黄色に変色した寒天は腐ったわけではなく、水に戻すと白くなります。
どちらの変化も経年による品質劣化ですが、食べられなくなるわけではないので大丈夫です。

子供がいると手軽に作れる寒天のデザートは定番です。
煮溶かして牛乳やフルーツを混ぜて冷やせばできあがりなので簡単ですよね。

賞味期限の長いフルーツ缶を買っておけば、思いついた時に作れます。
ほかにも寒天はダイエット食品としても人気がありますよね。
ではなぜ寒天がダイエットにおすすめなのでしょうか。
食物繊維の宝庫「寒天」のダイエット効果が凄すぎる!
寒天をダイエット中の食材におすすめできる理由としては、次の4つが挙げられます。
- 食物繊維が豊富に含まれていて腸内環境を整えてくれる
- 胃の中で膨張し満腹感を得やすい
- 血糖値の上昇を抑えてくれる
- カロリーが低い
この中でも一番の特徴としては、食物繊維が豊富に含まれている点です。

寒天に含まれる食物繊維とは
寒天は食物繊維の宝庫と言われますが、さらに凄いのは水溶性食物繊維と不溶性食物繊維の両方が含まれていることです。
- 水溶性食物繊維・・・腸内環境を整えてくれる
- 不溶性食物繊維・・・腸のぜん動運動を活発にしてくれる
二種類の食物繊維が含まれている寒天を食べることで、
- お通じが良くなり便秘が解消される
- デトックス効果が得られる
このような嬉しい効果が期待できるのですね。

食物繊維以外にもダイエット効果が期待できる理由
さらに寒天は保水力があるので、胃の中で水分を含んで膨らみます。
食物繊維と保水力のある寒天を食べることで、満腹感を得られて食事の量を減らせるので、ダイエット効果が期待できます。
さらには寒天は100gあたり2~3kcalととても低カロリーなので、食事全体のカロリーを抑える役割も担ってくれます。
また血糖値が上昇すると糖が吸収され脂肪を貯めやすくなりますが、寒天には血糖値の上昇を抑える働きがあるからダイエットに最適だといえます。

ただしダイエット目的の場合は、寒天に砂糖をたっぷり入れたりフルーツたくさん入れたデザートは効果が減ってしまうので注意しましょう。
まとめ
最後にここまでの内容を簡単にまとめておきましょう。
- 乾物の寒天は賞味期限をあまり気にしなくてもよい
- 常温保存で直射日光や高温多湿を避ける
- 棒や細寒天は袋に入れて保存する
- 粉寒天は密閉容器に入れて保存する
- 水に戻した寒天は冷蔵保存で2日~3日が目安
- 寒天が腐るとカビが生えて水っぽくなる
- 寒天は冷凍保存できない
- 寒天は食物繊維が豊富
- 低カロリーで満腹感もあるためダイエットに最適
寒天だけでなくしいたけもそうですが、乾物は水分を徹底的に蒸発させているから日持ちします。
今回、この記事を書くにあたって寒天についていろいろ調べてきましたが、天然の寒天はこんなに手間暇かけた製造工程なんだ!と驚きすらありました。
昔アルバイトしていた喫茶店で出していたコーヒーゼリーがとても美味しくて大好きになったのですが、どれでも美味しいわけではありません。

やっぱり、いい素材を使ってつくったものは美味しいのですよね。
しばらく寒天を放置してしまっていた私ですが、またダイエットも兼ねて寒天で何か作りたくなってきました。
もちろんコーヒーゼリーを作る時は、砂糖控えめで作りますよ。
この記事を読んだ方もぜひ試してみてはいかがでしょうか。


